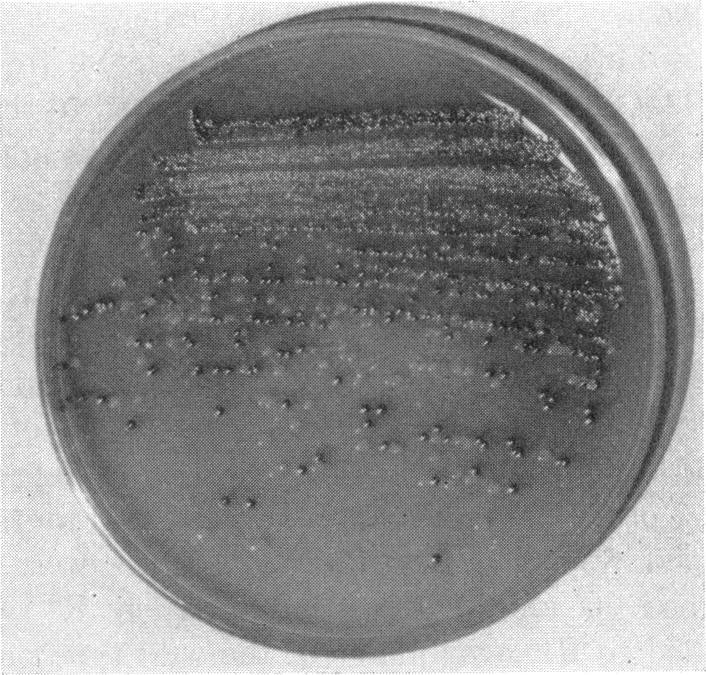
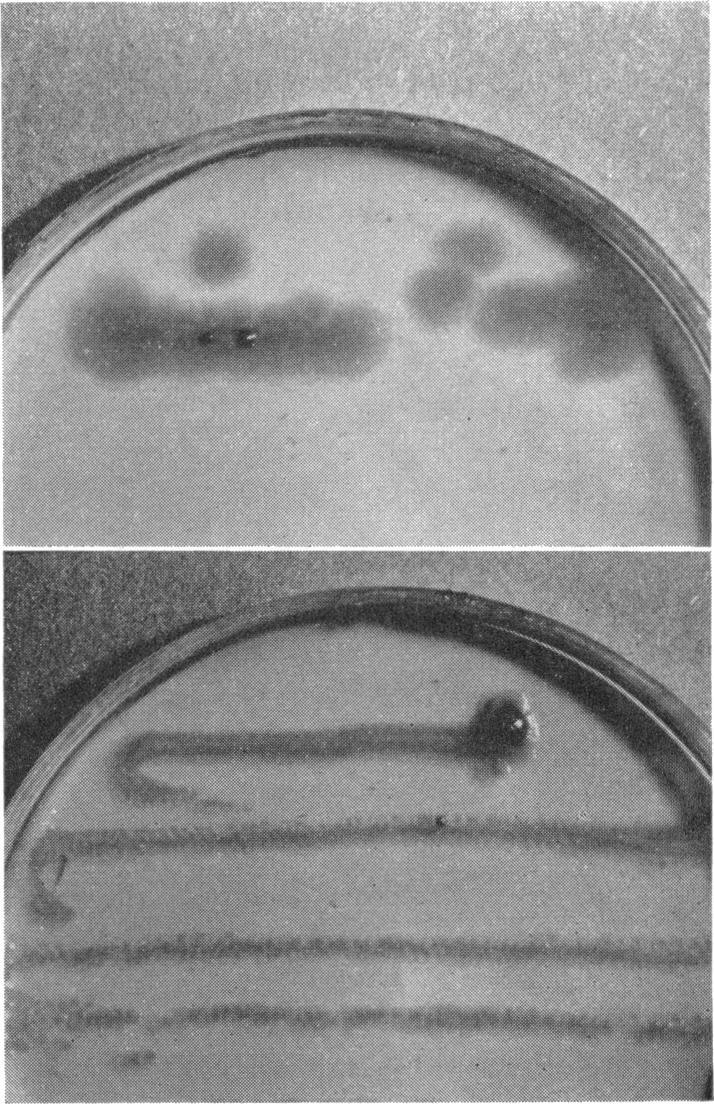

Mutation to rhamnose utilization in Pasteurella pestis.
作者信息
ENGLESBERG E
出版信息
J Bacteriol. 1957 May;73(5):641-8. doi: 10.1128/jb.73.5.641-648.1957.
Abstract
摘要
相似文献
1
Mutation to rhamnose utilization in Pasteurella pestis.
J Bacteriol. 1957 May;73(5):641-8. doi: 10.1128/jb.73.5.641-648.1957.
2
Physiological basis for rhamnose utilization by a mutant of Pasteurella pestis. II. A single mutational event leading to the production of two enzymes.
Arch Biochem Biophys. 1957 Sep;71(1):179-93. doi: 10.1016/0003-9861(57)90020-6.
3
Physiological basis for rhamnose utilization by a mutant of Pasteurella pestis. I. Experiments with resting cells; the isolation of lactic aldehyde.
J Bacteriol. 1957 Jul;74(1):8-11. doi: 10.1128/jb.74.1.8-11.1957.
4
[Behavior of Pasteurella pestis in relation to rhamnose; in reference to the report of E.R. Brygoo and J. Courdurier].
Ann Inst Pasteur (Paris). 1956 Aug;91(2):263-7.
5
[Quantitative study of the utilization of glucides by Pasteurella pestis strain E. V. in non proliferating suspension. I. Rhamnose].
Ann Inst Pasteur (Paris). 1959 Aug;97:245-7.
6
[Behavior of Madagascan strains of Pasteurella pestis in regard to rhamnose].
Ann Inst Pasteur (Paris). 1955 Dec;89(6):688-92.
7
Mutation to L-rhamnose resistance and transduction to L-rhamnose utilization in Salmonella typhosa.
J Bacteriol. 1959 Nov;78(5):675-86. doi: 10.1128/jb.78.5.675-686.1959.
8
A specific polysaccharide of Pasteurella pestis.
Biochem J. 1956 May;63(1):105-16. doi: 10.1042/bj0630105.
9
Metabolic reaction of Pasteurella pestis. II. The fermentation of glucose.
J Bacteriol. 1955 Mar;69(3):298-302. doi: 10.1128/jb.69.3.298-302.1955.
引用本文的文献
1
Recent findings regarding maintenance of enzootic variants of Yersinia pestis in sylvatic reservoirs and their significance in the evolution of epidemic plague.
Vector Borne Zoonotic Dis. 2010 Jan-Feb;10(1):85-92. doi: 10.1089/vbz.2009.0043.
2
Mutations Influencing the Assimilation of Nitrogen by Yersinia pestis.
Infect Immun. 1971 Apr;3(4):580-8. doi: 10.1128/iai.3.4.580-588.1971.
3
Microevolution and history of the plague bacillus, Yersinia pestis.
Proc Natl Acad Sci U S A. 2004 Dec 21;101(51):17837-42. doi: 10.1073/pnas.0408026101. Epub 2004 Dec 14.
4
The recent emergence of plague: a process of felonious evolution.
Microb Ecol. 2004 Apr;47(3):293-9. doi: 10.1007/s00248-003-1022-y. Epub 2004 Mar 25.
5
A review of recent literature on plague.
Bull World Health Organ. 1960;23(2-3):313-400.
6
Factors promoting acute and chronic diseases caused by yersiniae.
Clin Microbiol Rev. 1991 Jul;4(3):309-24. doi: 10.1128/CMR.4.3.309.
7
Consequences of aspartase deficiency in Yersinia pestis.
J Bacteriol. 1978 Nov;136(2):757-64. doi: 10.1128/jb.136.2.757-764.1978.
本文引用的文献
1
Spontaneous Mutation in Non-Dividing Bacteria.
Genetics. 1955 Sep;40(5):726-38. doi: 10.1093/genetics/40.5.726.
2
The Delayed Appearance of Radiation-Induced Genetic Change in Bacteria.
Genetics. 1953 Mar;38(2):134-51. doi: 10.1093/genetics/38.2.134.
3
Mutations during the Growth of Biochemical Mutants of Escherichia Coli.
Genetics. 1949 Jan;34(1):72-91. doi: 10.1093/genetics/34.1.72.
4
Delayed Phenotypic Expression of Spontaneous Mutations in Escherichia Coli.
Genetics. 1948 Sep;33(5):447-76. doi: 10.1093/genetics/33.5.447.
5
Mutations of Bacteria from Virus Sensitivity to Virus Resistance.
Genetics. 1943 Nov;28(6):491-511. doi: 10.1093/genetics/28.6.491.
6
THE RELATIONSHIP BETWEEN GROWTH AND MUTATION IN PSEUDOMONAS FLUORESCENS.
J Bacteriol. 1949 Aug;58(2):171-80.
7
GROWTH INHIBITION OF EBERTHELLA TYPHOSA BY CERTAIN CARBOHYDRATES AND ITS RELEASE BY MUTATION.
J Bacteriol. 1949 Jul;58(1):103-9. doi: 10.1128/jb.58.1.103-109.1949.
8
The mutagenic action of formaldehyde on bacteria.
J Bacteriol. 1952 Jan;63(1):1-11. doi: 10.1128/jb.63.1.1-11.1952.
9
[Behavior of Pasteurella pestis in relation to rhamnose; in reference to the report of E.R. Brygoo and J. Courdurier].
Ann Inst Pasteur (Paris). 1956 Aug;91(2):263-7.
10
[Behavior of Madagascan strains of Pasteurella pestis in regard to rhamnose].
Ann Inst Pasteur (Paris). 1955 Dec;89(6):688-92.